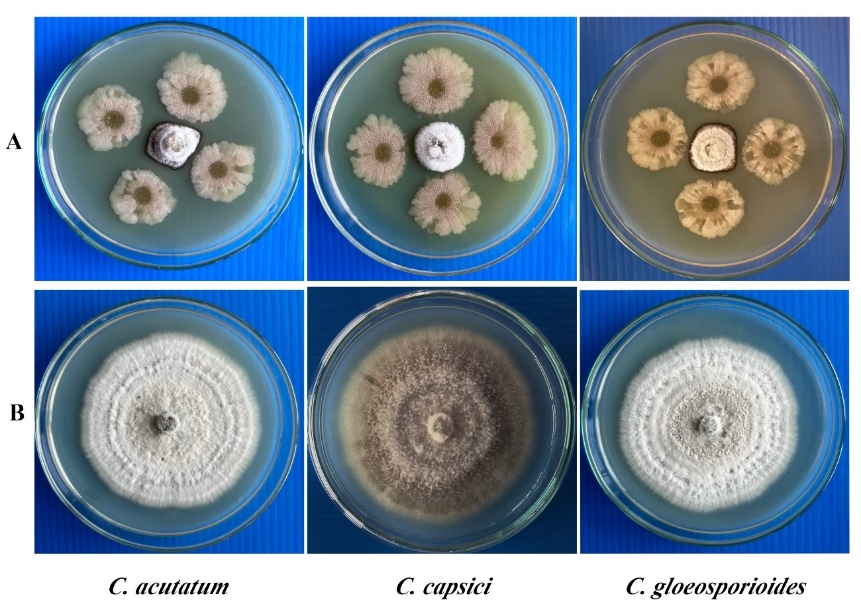
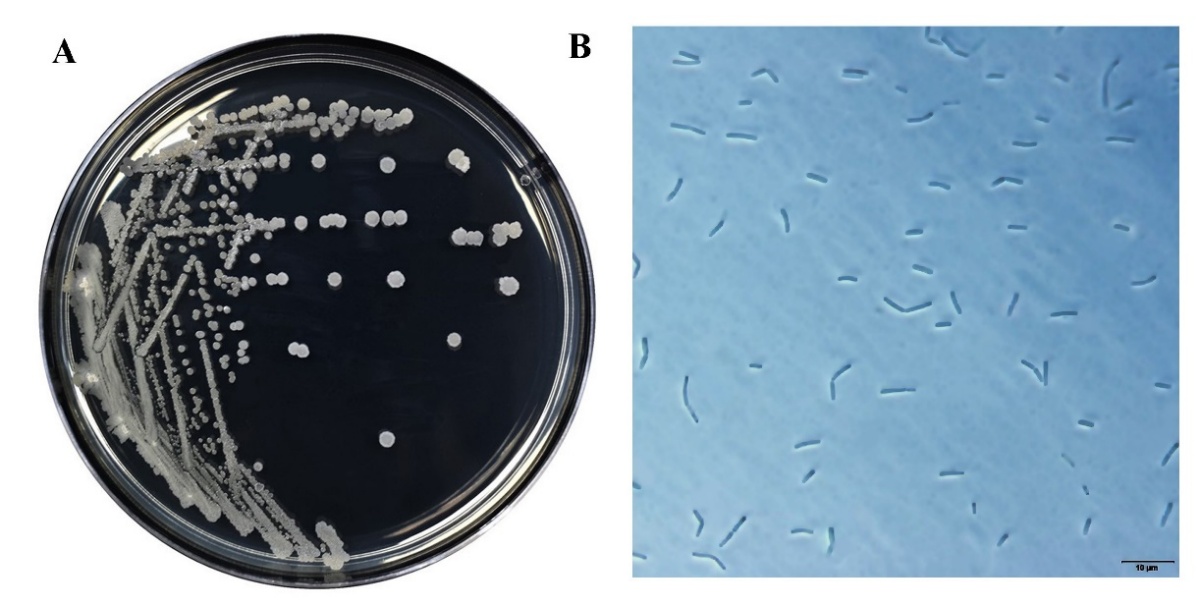

Trends
Sci.
2026; 23(5): 11729
Potential of Bacillus sp. SNRUSA9 for Suppressing Anthracnose and Promoting Growth in Chili
Aroon Wongjiratthiti and Suwapha Sawiphak*
Program of Biology, Faculty of Science and Technology, Sakon Nakhon Rajabhat University,
Sakon Nakhon 47000, Thailand
(*Corresponding author’s e-mail: [email protected])
Received: 29 August 2025, Revised: 9 September 2025, Accepted: 16 September 2025, Published: 1 January 2026
Abstract
Anthracnose is a major disease affecting chili production and leads to a decrease in crop yield. Farmers have increased their use of chemical agents to agricultural problems. However, the rising use of agricultural chemicals poses risks to human health and the environment. This research focused on assessing the efficacy of the bacterial isolate SNRUSA9 in controlling Colletotrichum acutatum, C. capsici, and C. gloeosporioides, responsible for anthracnose, and to assess its plant growth-promoting traits. SNRUSA9 exhibited strong antagonistic activity against all three pathogens and produced disease-suppressing compounds, including amylase, cellulase, chitinase, lipase, protease, siderophores, and biofilm. It also exhibited plant growth-promoting properties through ammonia production, indole-3-acetic acid synthesis, and phosphate solubilization. SNRUSA9 was identified as a Bacillus species, and designated Bacillus sp. SNRUSA9. Pot experiments confirmed its effectiveness in significantly reducing anthracnose incidence and enhancing chili growth, fresh weight, dry weight, and shoot length, compared to the control. The study highlights the potential of Bacillus sp. SNRUSA9 for disease suppression and chili growth promotion.
Keywords: Biological control, Antagonistic bacteria, Plant growth promoting bacteria, Biocontrol agent, Bacillus, Colletotrichum acutatum, Colletotrichum capsici, Colletotrichum gloeosporioides
Introduction
Agriculture has long been a fundamental part of human livelihood. However, in recent decades, numerous challenges have contributed to declining crop yields and, in some cases, total crop failure. Among the most significant and persistent problems is plant disease, a biotic factor that poses serious threats to crop productivity [1]. These diseases are caused by a variety of microorganisms, including fungi, bacteria, and Oomycetes [2]. Among these microorganisms, around 8,000 fungal species are known to infect crop plants. Fungal plant pathogens can invade and destroy plant tissues at all stages of plant growth, thereby complicating detection and effective control [3]. Chemical agents are commonly used for plant disease control because of their effectiveness, rapid action, and ease of application. However, excessive use has raised serious concerns, particularly regarding human health.
Residues can accumulate in the body, causing acute or chronic illnesses, and in severe cases, death. Moreover, these chemicals can harm the environment and non-target organisms beyond the intended pathogens [4]. Anthracnose disease is a severe plant disease that significantly damages chili pepper (Capsicum annuum L.), leading to substantial reductions in both yield and fruit quality [5]. The disease is caused by fungal pathogens in the genus Colletotrichum. In Thailand, severe outbreaks caused by C. acutatum [6], C. capsici, and C. gloeosporioides have been reported [7]. Anthracnose disease commonly occurs under high humidity conditions and can infect chili plants at all growth stages. Infections on petioles and fruit stems often result in leaf and fruit drop, causing severe production losses [8]. Biological control is widely recognized as an effective and environmentally friendly substitute to harmful chemicals, promoting safer agriculture [9]. Bacillus species are notable for producing antimicrobial compounds and modulating nutrients and hormones, enhancing their ability to control diseases and promote plant growth. Several Bacillus species have been reported to effectively manage many fungal diseases [10], and stimulate plant growth [11,12]. Moreover, Bacillus species can produce spores, allowing them to survive various environmental stresses such as salinity, drought, nutrient imbalances, extreme temperatures, and exposure to both organic and inorganic pollutants. Therefore, this group of bacteria is highly suitable for agricultural applications [13].
An unpublished preliminary study showed that the bacterial isolate SNRUSA9, isolated from liquid biofertilizer, effectively inhibited the mycelial growth of C. acutatum, C. capsici, and C. gloeosporioides by the dual culture method. Therefore, our research aimed to investigate the potential of bacterial isolate SNRUSA9 to suppress disease and promote chili growth through laboratory and pot experiments, confirming its suitability as a biocontrol agent and its role in supporting sustainable chili cultivation.
Materials and methods
Microorganisms preparation
SNRUSA9 effectively inhibited the mycelial growth of C. acutatum, C. capsici, and C. gloeosporioides, with inhibition rates of 71.21%, 70.86% and 69.99%, respectively (Figure 1). SNRUSA9 was cultured in Peptone Yeast Extract Glucose (PYG) broth (0.7% peptone, 0.7% yeast extract, and 0.5% glucose; w/v) at 37 °C with shaking at 160 rpm for 24 h. Cells were harvested by centrifugation at 5,635×g for 10 min at 4 °C, washed three times with sterile distilled water, and resuspended in sterile water to an OD₆₀₀ of 1.0 (~1×10⁹ CFU/mL).
Fungal pathogen isolates (C. acutatum, C. capsici, and C. gloeosporioides) were sourced from the Plant Protection Research and Development Office, Department of Agriculture, Bangkok, Thailand. Each isolate was grown on Potato Dextrose Agar (PDA; Difco™) at 28 °C for 7 days. Spores were collected by adding 10 mL sterile distilled water to the culture surface, gently scraping with a sterile glass rod, and filtering through three layers of sterile cheesecloth. Spore concentration was measured with a hemocytometer and adjusted to 1×10⁷ spores/mL.
Figure 1 Efficiency of the bacterial isolate SNRUSA9 against C. acutatum, C. capsici, and C. gloeosporioides (A), and the untreated control group (B).
Biocontrol properties investigation
Siderophore production was determined according to Shen et al. [14]. A 2 µL inoculum of SNRUSA9 was spotted onto Chrome Azurol S (CAS) medium and incubated at 37 °C for 3 days. Following incubation, yellow halos formed around the colonies, indicating siderophore production. The production of extracellular lytic enzymes by SNRUSA9, including amylase, cellulase, lipase, protease, and chitinase, was assessed following Kwon et al. [15]. A 2 µL inoculum was spotted onto selective media and incubated at 37 °C for 2 days. Enzyme activity was indicated by clear zones surrounding the bacterial colonies. The enzymes were tested using starch agar, carboxymethyl cellulose sodium (CMC-Na) agar, tributyrin agar, skim milk agar, and colloidal chitin agar, respectively.
Biofilm production was assessed following Nair et al. [16]. A 100 µL inoculum of SNRUSA9 was added to 1 mL PYG broth in glass tubes and incubated statically at 37 °C for 8 days. An uninoculated tube served as control. After incubation, the medium was discarded, tubes washed twice with phosphate-buffered saline (pH 7.3), air-dried, and stained with 0.1% crystal violet for 5 min. Stain was discarded, tubes rinsed twice with sterile distilled water. Biofilm formation was shown by crystal violet staining on the tube surface.
Plant growth-promoting properties investigation
The ammonia concentration was measured using the method of Fahsi et al. [17]. Briefly, 100 µL of SNRUSA9 inoculum was added to 4% peptone broth and incubated at 37 °C with shaking at 160 rpm for 2 days. Then, 0.5 mL of Nessler’s reagent was added to 2.5 mL of the supernatant, mixed thoroughly, and allowed to react for 10 min before measuring the absorbance at 420 nm. The ammonia concentration was determined by comparing the absorbance to a standard curve prepared with ammonium sulfate.
The IAA concentration was measured using the method of Soponputtaporn et al. [18]. A 100 µL inoculum of SNRUSA9 was added to 100 mL of PYG broth supplemented with 50 mg/100 mL L-tryptophan and incubated at 37 °C with shaking at 160 rpm for 2 days. After incubation, 2 mL of Salkowski’s reagent was added to 1 mL of the supernatant, mixed, and kept in the dark at room temperature for 30 min. The absorbance was measured at 535 nm to determine the IAA concentration by comparison with an IAA standard curve.
Phosphate solubilization was tested following the method of Mazylyte et al. [19]. A 2 µL inoculum of SNRUSA9 was dropped onto Pikovskaya (PVK) medium and incubated at 37 °C for 5 days. The appearance of a clear zone around the colony was observed to confirm phosphate solubilization ability.
Identification of bacterial isolate SNRUSA9
The strain SNRUSA9 was identified using morphological, biochemical, and molecular approaches. Morphological characteristics were observed using imaging equipment and a phase-contrast light microscope at 1,000x magnification. Biochemical identification was conducted using the VITEK 2 Compact system. For molecular analysis, genomic DNA was extracted from the bacterial isolate using a commercial extraction kit (Geneaid Biotech Ltd., Taiwan). The 16S rRNA gene was amplified by polymerase chain reaction (PCR), and the resulting PCR product was sequenced. The obtained sequence was aligned with sequences in the GenBank database using BLAST (The Basic Local Alignment Search Tool) to identify the bacterial strain. Subsequently, the evolutionary relationship of the isolate was analyzed by constructing a phylogenetic tree using MEGA version 7.0 (http://www.megasoftware.net). The neighbor-joining method was employed to generate the tree, and evolutionary distances were calculated using the Maximum Composite Likelihood method. The tree’s reliability was tested by performing 1,000 bootstrap replications. Molecular procedures followed the method described by Sawiphak and Wongjiratthiti [20].
Efficacy of SNRUSA9 on anthracnose and chili growth in a pot experiment
The efficacy of SNRUSA9 on anthracnose control and chili growth was evaluated in a pot experiment conducted in an open greenhouse at Sakon Nakhon Rajabhat University, Thailand, from November to December 2023. The average temperature and relative humidity in November were 26.2 °C and 73.2%, respectively, while in December, the average temperature and relative humidity were 24.5 °C and 72.6%, respectively. Sixty days after planting, the efficacy of SNRUSA9 was evaluated for controlling anthracnose disease caused by C. acutatum, C. capsici, and C. gloeosporioides, as well as for promoting the growth of Jinda Red chili. Seeds were sterilized with 1.0% NaOCl for 2 min and rinsed thrice with sterile water. Peat moss was autoclaved at 121 °C for 20 min. The experiment consisted of 4 treatments. Treatment 1 (T1) served as the control, without SNRUSA9 or fungal pathogen inoculation. Treatment 2 (T2) received only SNRUSA9, while Treatment 3 (T3) received only the fungal pathogen. Treatment 4 (T4) was inoculated with both SNRUSA9 and the fungal pathogen. Twenty chili seeds were sown in pots containing sterile peat moss mixed with 1.2 g of 15-15-15 chemical fertilizer per pot. In T2 and T4, 50 mL of SNRUSA9 suspension (OD₆₀₀ = 1.0) was applied on Days 0, 1, 2, 20 and 35. T3 and T4 were treated with 50 mL of fungal spore suspension on Day 0. All plants were irrigated daily with 200 mL of sterile distilled water. At 60 days, the efficacy of SNRUSA9 in controlling chili anthracnose and promoting plant growth was assessed. The percentage of disease incidence (% DI) was calculated using the following formula, and growth parameters such as root/shoot length and fresh and dry weight were measured.
% DI = (Number of infected plants / Total number of plants) × 100 (1)
Statistical analysis
Multiple group comparisons were performed using one-way ANOVA followed by Tukey’s HSD post-hoc test, and p values less than 0.05 were considered statistically significant. Data analysis was conducted using SPSS version 29.
Results and discussion
Biocontrol properties of SNRUSA9
To evaluate the biocontrol potential of SNRUSA9, its ability to produce siderophores, extracellular lytic enzymes, and biofilms was examined. These properties are known to contribute to the antagonistic activity of beneficial microbes against plant pathogens. The results highlight mechanisms by which SNRUSA9 inhibits fungal pathogens.
Siderophore production by SNRUSA9 was qualitatively assessed using CAS medium. After 3 days of incubation, a color change from green to yellow in the medium surrounding the colonies indicated a positive result, implying the production and secretion of siderophores by the isolate (Figure 2(A)). It is encouraging that this study demonstrates SNRUSA9 as another Bacillus strain capable of producing siderophores [15,21]. Siderophores produced by Bacillus spp. effectively chelate iron from the environment, outcompeting phytopathogens for this essential nutrient and thereby inhibiting their growth. Moreover, these siderophores enhance iron uptake by plants, especially in soils where iron is present in insoluble forms [11].
Enzymatic activities of SNRUSA9 were demonstrated by the formation of clear zones around the colonies after 2 days of incubation, including amylase (Figure 2(B)), cellulase (Figure 2(C)), lipase (Figure 2(D)), protease (Figure 2(E)) and chitinase (Figure 2(F)). The production of extracellular lytic enzymes by strain SNRUSA9 is a key factor in inhibiting the growth of the fungal pathogen. These enzymes degrade key structural components of fungal cell walls, effectively inhibiting fungal growth [22,23]. Amylase breaks down starch in the fungal cell wall into simple sugars, enhancing overall cell wall degradation. Cellulase plays a crucial role in the hydrolysis of cellulose, while chitinase is an enzyme that breaks down chitin. Both cellulose and chitin are components of the fungal cell wall, and their degradation leads to damage of the wall structure. Lipase functions to break down lipids on the fungal cell surface. Once the lipids are degraded, other enzymes such as cellulase and chitinase can access and degrade the fungal cell wall more effectively. Protease degrades glycoproteins, which are also components of the fungal cell wall, resulting in structural damage and reduced integrity. This causes cell lysis and leakage of intracellular contents, ultimately inhibiting the growth of pathogenic fungi [24].
SNRUSA9 was capable of forming biofilms, as indicated by crystal violet staining on the inner surface of the test tube after 8 days of incubation (Figure 2(G)). Experimental results indicated that SNRUSA9 could inhibit the anthracnose-causing fungus, possibly due to its biofilm formation. This finding is consistent with previous reports stating that bacterial biofilms help control plant diseases by adhering to plant roots and effectively competing with pathogens for space and nutrients. Moreover, the biofilm acts as a protective barrier that prevents pathogen invasion of plant surfaces and significantly reduces infection [25].

Figure 2 Potential biocontrol and plant growth-promoting properties of the bacterial isolate SNRUSA9 include siderophore production (A), amylase (B), cellulase (C), lipase (D), protease (E), chitinase (F), biofilm formation (G), and phosphate solubilization (H).
Plant growth-promoting properties of SNRUSA9
The assessment of ammonia and IAA production by SNRUSA9 revealed that after 2 days of incubation, SNRUSA9 produced 1.18 µmol/mL of ammonia in peptone broth and 9.27 µg/mL of IAA in PYG broth supplemented with L-tryptophan. Bacterial ammonia production contributes to nitrogen mineralization in soil, which enhances nitrogen uptake by plants, thereby promoting root and shoot development, biomass accumulation, and overall plant growth [26]. IAA, a plant hormone belonging to the auxin group, can be synthesized by bacteria using L-tryptophan as a precursor. IAA plays a critical role in stimulating plant cell elongation and division; promoting the formation of adventitious and lateral roots; improving water and nutrient uptake under environmental stress, and facilitating nutrient transport, resulting in enhanced overall plant growth efficiency [27].
The phosphate-solubilizing ability of SNRUSA9 was evaluated, and it was found that SNRUSA9 could solubilize phosphate after 5 days of incubation. A clear halo zone was observed around the colony on a PVK medium containing tricalcium phosphate (Figure 2(H)). This indicates that SNRUSA9 can convert insoluble phosphate into a soluble form usable by plants. Phosphate-solubilizing bacteria thus enhance phosphorus availability and uptake, which are essential for root development, and additionally help plants tolerate and resist various stress factors. Improved phosphorus acquisition promotes better root architecture by stimulating lateral and adventitious root growth, thereby increasing root surface area. These changes improve the plant’s capacity to absorb water and nutrients, thereby supporting its overall growth [28,29]. Based on these results, SNRUSA9 is suggested to exhibit characteristics of a beneficial bacterium that promotes plant growth.
Identification of SNRUSA9
The morphology of SNRUSA9 displayed whitish, raised colonies featuring irregular margins (Figure 3(A)) when grown on tryptic soy agar (TSA) at 37 °C for 18 h. Phase-contrast microscopy further demonstrated that strain SNRUSA9 exhibited a rod-shaped morphology and was capable of producing spores (Figure 3(B)). Biochemical characterization using the VITEK 2 Compact system revealed that SNRUSA9 exhibited a profile similar to that of Bacillus species (Table 1). Based on 16S rDNA gene sequence analysis, strain SNRUSA9 exhibited high similarity to B. velezensis (99.90%), B. siamensis (99.70%), B. amyloliquefaciens (99.60%), and B. subtilis (99.50%). However, phylogenetic reconstruction using the neighbor-joining method revealed that SNRUSA9 forms a distinct clade, separate from B. velezensis and closely related taxa (Figure 4), suggesting that it may represent a putative novel species within the genus Bacillus. The obtained nucleotide sequence was deposited in the GenBank database under accession number PQ409447. Molecular analysis revealed that Bacillus sp. SNRUSA9 exhibits high similarity with B. velezensis, B. amyloliquefaciens, and B. subtilis, all of which have been recognized as generally recognized as safe (GRAS) [30]. These findings suggest that Bacillus sp. SNRUSA9 is likely safe and can be used safely in agricultural applications.
Figure 3 Morphological characteristics on tryptic soy agar at 37 °C for 18 h. (A), cell shape under phase-contrast microscopy at 1,000x magnification (B) of the bacterial isolate SNRUSA9.
Table 1 Biochemical characteristics of the bacterial isolate SNRUSA9.
Characteristics |
Reaction |
Characteristics |
Reaction |
-xylosidase |
+ |
Maltotriose |
‒ |
L-lysine arylamidase |
‒ |
Glycine arylamidase |
+ |
L-aspartate arylamidase |
‒ |
D-mannitol |
‒ |
Leucine arylamidase |
‒ |
D-mannose |
+ |
Phenylalanine arylamidase |
+ |
D-melezitose |
‒ |
L-proline arylamidase |
‒ |
N-acetyl-D-glucosamine |
‒ |
-galactosidase |
‒ |
Palatinose |
‒ |
L-pyrrolidonyl arylamidase |
+ |
L-rhamnose |
‒ |
-galactosidase |
+ |
-glucosidase |
+ |
Alanine arylamidase |
+ |
-mannosidase |
+ |
Tyrosine arylamidase |
+ |
Phosphoryl choline |
‒ |
-N-acetyl-glucosaminidase |
‒ |
Pyruvate |
+ |
Ala-Phe-Pro arylamidase |
‒ |
-glucosidase |
+ |
Cyclodextrine |
‒ |
D-tagatose |
‒ |
D-galactose |
‒ |
D-trehalose |
+ |
Glycogene |
(‒) |
Inulin |
‒ |
Myo-inositol |
‒ |
D-glucose |
+ |
Methyl- -D-glucopyranoside acidification |
(+) |
D-ribose |
‒ |
Ellman |
(‒) |
Putrescine assimilation |
‒ |
Methyl-D-xyloside |
‒ |
Growth in 6.5% NaCl |
(‒) |
-mannosidase |
‒ |
Kanamycin resistance |
‒ |
Tetrazolium red |
+ |
Oleandomycin resistance |
‒ |
Polymixin_B resistance |
+ |
Esculin hydrolyse |
+ |
Remark; + = Positive reaction, ‒ = Negative reaction, (+) = Weak-positive reaction, (‒) = Weak- negative reaction.

Figure 4 Neighbor-joining tree based on 16S rRNA gene sequences showing the phylogenetic relationships of bacterial isolate SNRUSA9 and related Bacillus species. Bootstrap values were calculated from 1,000 replications.
Efficacy of Bacillus sp. SNRUSA9 on anthracnose control and chili growth promotion in a pot experiment
In evaluating the efficacy of Bacillus sp. SNRUSA9 in controlling anthracnose caused by C. acutatum, C. capsici, and C. gloeosporioides, as well as in promoting chili growth under pot experiment conditions, it was observed that a 60 days after transplanting, anthracnose symptoms occurred in all treatments, including those uninoculated with the pathogens. Disease development in Treatment 1 (T1) and Treatment 2 (T2) may be attributed to the open-pot experiment, which lacked contamination control measures. The planting period coincided with the winter season. In the early morning, there is fog and dew on the plant leaves, creating an environment conducive to the occurrence of fungal pathogens [31]. All three fungal species can produce asexual spores (conidia), which are easily dispersed by wind. The environmental conditions during the experiment, with an average temperature of 25.35 °C and high relative humidity of 72.9%, may have favored fungal growth and increased pathogenicity [32]. In Treatment 3 (T3), which was inoculated only with pathogenic fungi without the biocontrol agent, the highest disease incidences were observed: 98.31% in the C. acutatum trial, 92.08% in the C. capsici trial, and 87.41% in the C. gloeosporioides trial. In contrast, Treatment 4 (T4), which received Bacillus sp. SNRUSA9, showed significantly lower disease incidences (p < 0.05), with values of 17.15%, 26.48% and 30.37% in the respective trials (Figure 5). The reduction in disease incidence may be attributed to the antagonistic mechanisms of Bacillus sp. SNRUSA9, which can compete with pathogenic fungi for nutrients and space through siderophore production and biofilm formation, as well as the secretion of antimicrobial compounds such as extracellular lytic enzymes. In addition to its ability to suppress disease, Bacillus sp. SNRUSA9 significantly promoted the growth of chili plants (p < 0.05), as demonstrated in (Figures 6 and 7). Chili plants treated with Bacillus sp. SNRUSA9 showed higher average fresh weight (Figure 6(A)), average dry weight (Figure 6(B)), and average shoot length (Figure 7(A)) compared to those that did not receive the Bacillus sp. SNRUSA9 treatment.

Figure 5 Percentage of disease incidence after treatment with Bacillus sp. SNRUSA9 and C. acutatum, C. capsici, and C. gloeosporioides, under pot experiment conditions for 60 days. The different lower-case letters indicate significant differences (p < 0.05) based on Tukey’s HSD test.

Figure 6 Plant growth promotion: Fresh weights (A) and dry weights (B) after treatment with Bacillus sp. SNRUSA9 and three Colletotrichum species under pot experiment conditions for 60 days. The different lower-case letters indicate significant differences (p < 0.05) based on Tukey’s HSD test.
These findings indicate that Bacillus sp. SNRUSA9 not only protects plants from pathogenic attacks but also enhances plant growth. This growth-promoting effect may result from multiple mechanisms, including ammonia production and the solubilization of insoluble phosphate, thereby enhancing the availability of essential nutrients (particularly nitrogen and phosphorus) to the plants, as well as the production of IAA. These findings are consistent with previous studies reporting that Bacillus species possess both biocontrol activity against anthracnose and plant growth-promoting capabilities. Woo et al. [33] found that Bacillus siamensis GP-P8 significantly reduced anthracnose disease incidence and promoted chili development through mechanisms similar to those observed with Bacillus sp. SNRUSA9. The root length of chili plants was not significantly different (p > 0.05) among all treatments (Figures 7(B)). This may be due to the pot experiment, where the limited area restricted the root system and provided no space for root elongation [34], resulting in no significant difference in chili root length.

Figure 7 Plant growth promotion: Shoot length (A), root length (B) after treatment with Bacillus sp. SNRUSA9 and three Colletotrichum species under pot experiment conditions for 60 days. The different lower-case letters indicate significant differences (p < 0.05) based on Tukey’s HSD test.
Conclusions
Bacillus sp. SNRUSA9 is a bacterium with potential for both plant disease control and plant growth promotion. It is capable of producing various bioactive compounds, including siderophores, extracellular lytic enzymes, and biofilm, which play a significant role in inhibiting C. acutatum, C. capsici, and C. gloeosporioides, the causal agent of anthracnose disease in chili. In addition, SNRUSA9 can produce ammonia, synthesize the plant hormone IAA, and solubilize phosphate, all of which contribute to plant growth promotion mechanisms. Phylogenetic analysis revealed that although Bacillus sp. SNRUSA9 is genetically related to Bacillus velezensis, it is distinctly separated into a different clade. This suggests the possibility that SNRUSA9 may represent a novel strain or possess unique genetic and biological characteristics different from known strains. A pot experiment demonstrated that Bacillus sp. SNRUSA9 significantly reduced the severity of anthracnose disease and promoted chili plant growth. However, to confirm its efficacy under complex and diverse real-world conditions, further investigation at the field level is recommended.
Acknowledgements
Thailand Science Research and Innovation (TSRI) and Sakon Nakhon Rajabhat University, Thailand, provided funding to support this research.
Declaration of Generative AI in Scientific Writing
The authors used ChatGPT to enhance the manuscriptʼs readability and language. The authors have reviewed and edited the content as necessary and take full responsibility for the content of this publication.
CRediT Author Statement
Aroon Wongjiratthiti: Conceptualization; Methodology; Validation; Formal analysis, Writing - Review & Editing, Project administration, Funding acquisition. Suwapha Sawiphak: Conceptualization; Methodology; Validation; Writing - Original draft preparation; Writing - Review & Editing, Project administration.
References
[1] Y Peng, SJ Li, J Yan, Y Tang, JP Cheng, AJ Gao, X Yao, JJ Ruan and BL Xu. Research progress on phytopathogenic fungi and their role as biocontrol agents. Frontiers in Microbiology 2021; 12, 670135.
[2] E Fiallo-Olive, A Palacio-Bielsa and S Sacristan. Plant pathogenic microorganisms: State-of-the-art research in Spain. Microorganisms 2023; 11(3), 816.
[3] G Hariharan and K Prasannath. Recent advances in molecular diagnostics of fungal plant pathogens: A mini review. Frontiers in Cellular and Infection Microbiology 2021; 10, 600234.
[4] W Zhou, M Li and V Achal. A comprehensive review on environmental and human health impacts of chemical pesticide usage. Emerging Contaminants 2025; 11(1), 100410.
[5] NY Ro, R Sebastin, OS Hur, GT Cho, B Geum, YJ Lee and BC Kang. Evaluation of anthracnose resistance in pepper (Capsicum spp.) genetic resources. Horticulturae 2021; 7(11), 460.
[6] TL Thanh, VK Cong, R Sangpueak, P Numparditsub, NK Papathoti, T Machikowa and K Buensanteai. Efficacy of Bacillus subtilis for controlling anthracnose in chilli. Agriculture and Natural Resources 2023; 57(2), 223-232.
[7] V Puripunyavanich, TN Nan, N Suwan, P Orpong, R Picha, L Maikaeo, A Tamman and T Bhasabuttra. Breeding for anthracnose disease resistance in chili pepper (Capsicum annum L.) using gamma irradiation. Trends in Sciences 2024; 21(8), 7709.
[8] BD Aljawasim, JB Samtani and M Rahman. New insights in the detection and management of anthracnose diseases in strawberries. Plants 2023; 12(21), 3704.
[9] M Villavicencio-Vasquez, F Espinoza-Lozano, L Espinoza-Lozano and J Coronel-Leon. Biological control agents: Mechanisms of action, selection, formulation and challenges in agriculture. Frontiers in Agronomy 2025; 7, 1578915.
[10] N Zhang, Z Wang, J Shao, Z Xu, Y Liu, W Xun, Y Miao, Q Shen and R Zhang. Biocontrol mechanisms of Bacillus: Improving the efficiency of green agriculture. Microbial Biotechnology 2023; 16(1), 2250-2263.
[11] D Miljakovic, J Marinkovic and S Balesevic-Tubic. The significance of Bacillus spp. in disease suppression and growth promotion of field and vegetable crops. Microorganisms 2020; 8(7), 1037.
[12] T Tsotetsi, L Nephali, M Malebe and F Tugizimana. Bacillus for plant growth promotion and stress resilience: What have we learned? Plants 2022; 11(19), 2482.
[13] H Etesami, BR Jeong and BR Glick. Potential use of Bacillus spp. as an effective biostimulant against abiotic stresses in crops—A review. Current Research in Biotechnology 2023; 5, 100128.
[14] N Shen, S Li, S Li, H Zhang and M Jiang. The siderophore-producing bacterium, Bacillus siamensis Gxun-6, has an antifungal activity against Fusarium oxysporum and promotes the growth of banana. Egyptian Journal of Biological Pest Control 2022; 32, 34.
[15] HT Kwon, Y Lee, J Kim, K Balaraju, HT Kim and Y Jeon. Identification and characterization of Bacillus tequilensis GYUN-300: An antagonistic bacterium against red pepper anthracnose caused by Colletotrichum acutatum in Korea. Frontiers in Microbiology 2022; 13, 826827.
[16] S Nair, N Kwatra and J Abraham. Isolation and characterization of biofilm producing bacteria from water treatment tank. Current Trends in Biotechnology and Pharmacy 2021; 15(6), 34-39.
[17] N Fahsi, I Mahdi, A Mesfioui, L Biskri and A Allaoui. Plant growth-promoting rhizobacteria isolated from the jujube (Ziziphus lotus) plant enhance wheat growth, Zn uptake, and heavy metal tolerance. Agriculture 2021; 11(4), 316.
[18] S Soponputtaporn, M Srithaworn, Y Promnuan, P Srirat and O Chunhachart. Indole-3-acetic acid producing yeasts in the phyllosphere of legumes: Benefits for chili growth. Trends in Sciences 2024; 21(3), 7335.
[19] R Mazylyte, J Kaziuniene, L Orola, V Valkovska, E Lastauskiene and A Gegeckas. Phosphate solubilizing microorganism Bacillus sp. MVY-004 and its significance for biomineral fertilizers’ development in agrobiotechnology. Biology 2022; 11(2), 254.
[20] S Sawiphak and A Wongjiratthiti. Optimisation of culture conditions for PLA-food-packaging degradation by Bacillus sp. SNRUSA4. Pertanika Journal of Science & Technology 2021; 29(1), 407-425.
[21] A Kumar, J Rabha and DK Jha. Antagonistic activity of lipopeptide-biosurfactant producing Bacillus subtilis AKP against Colletotrichum capsici, the causal organism of anthracnose disease of chilli. Biocatalysis and Agricultural Biotechnology 2021; 36, 102133.
[22] H Huang, C Tian, Y Huang and H Huang. Biological control of poplar anthracnose caused by Colletotrichum gloeosporioides (Penz.) Penz. & Sacc. Egyptian Journal of Biological Pest Control 2020; 30, 104.
[23] Y Yanti, H Hamid, Reflin and Yaherwandi. The ability of chitinolytic bacteria to control Colletotrichum capsici in chili plants. IOP Conference Series: Earth and Environmental Science 2023; 1228(1), 012020.
[24] HB Ajuna, HI Lim, JH Moon, SJ Won, V Choub, SI Choi, JY Yun and YS Ahn. The prospect of hydrolytic enzymes from Bacillus species in the biological control of pests and diseases in forest and fruit tree production. International Journal of Molecular Sciences 2023; 24(23), 16889.
[25] N Ajijah, A Fiodor, AK Pandey, A Rana and K Pranaw. Plant growth-promoting bacteria (PGPB) with biofilm-forming ability: A multifaceted agent for sustainable agriculture. Diversity 2023; 15(1), 112.
[26] A Fanai, B Bohia, F Lalremruati, N Lalhriatpuii, L Lalrokimi, R Lalmuanpuii, PK Singh and Zothanpuia. Plant growth promoting bacteria (PGPB)-induced plant adaptations to stresses: An updated review. PeerJ 2024; 12, 17882.
[27] H Etesami and BR Glick. Bacterial indole-3-acetic acid: A key regulator for plant growth, plant-microbe interactions, and agricultural adaptive resilience. Microbiological Research 2024; 281, 127602.
[28] L Pan and B Cai. Phosphate-solubilizing bacteria: Advances in their physiology, molecular mechanisms and microbial community effects. Microorganisms 2023; 11(12), 2904.
[29] C Wang, G Pan, X Lu and W Qi. Phosphorus solubilizing microorganisms: Potential promoters of agricultural and environmental engineering. Frontiers in Bioengineering and Biotechnology 2023; 11, 1181078.
[30] V Karacic, D Miljakovic, J Marinkovic, M Ignjatov, D Milosevic, G Tamindzic and M Ivanovic. Bacillus species: Excellent biocontrol agents against tomato diseases. Microorganisms 2024; 12(3), 457.
[31] J Detka, M Jafari, M Gomez and GS Gilbert. Machine learning vs. empirical models: Estimating leaf wetness patterns in a wildland landscape for plant disease management. Agricultural and Forest Meteorology 2025; 362, 110392.
[32] MM Hossain, F Sultana, M Mostafa, H Ferdus, M Rahman, JA Rana, SS Islam, S Adhikary, A Sannal, MAE Hosen, J Nayeema, NJ Emu, M Kundu, SK Biswas, L Farzana and MAA Sabbir. Plant disease dynamics in a changing climate: Impacts, molecular mechanisms, and climate‑informed strategies for sustainable management. Discover Agriculture 2024; 2, 132.
[33] JM Woo, HS Kim, IK Lee, EJ Byeon, WJ Chang and YS Lee. Potentiality of beneficial microbe Bacillus siamensis GP-P8 for the suppression of anthracnose pathogens and pepper plant growth promotion. Plant Pathology Journal 2024; 40(4), 346-357.
[34] A Zhang and Q Shang. Transcriptome analysis of early lateral root formation in tomato. Plants 2024; 13(12), 1620.